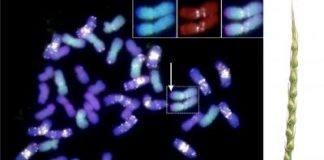
Biology: Global collaboration is unlocking wheat’s genetic potential

James M. Patterson
8343 POSTS
0 COMMENTS
4646 Badger Pond Lane
Tampa, FL 33610
727-342-7586
Almost all Tdnews staff, including reporters, can be contacted by e-mail.
In most cases the e-mail address follows this formula: first initial + last name + @tunisiesoir.com. For example, Laura F. Nixon is [email protected]
Top News
Hey ISIS, You Suck: Local Muslims Post Anti-ISIS Billboard
A new billboard on Manchester Road in Missouri reads, "HEY ISIS, YOU SUCK!!! From: #ActualMuslims."
A group of Muslim-Americans have put up a blunt billboard...